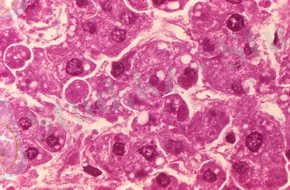
https://im3-tub-kz.yandex.net/i?id=c4b2703cd8945f958080a70ab9f571e6&n=33&h=190&w=290

Қызба: патогенезі, даму сатылары және геморрагиялық қызбалардың клиникасы


Қазақстан Республикасы Білім және Ғылым Министрлігі
Семей қаласының Шәкәрім атындағы Мемлекеттік Университеті.
БӨЖ
Тақырыбы: Лихорадка
Орындаған: Онгарова Д. Б
Тобы: ВС-303
Тексерген: Нуркенова М. К.
Семей 2015ж
Жоспар:
І. Кіріспе:
Қызба
ІІ. Негізгі бөлім:
2. 1 . Қызбаның сатылары
2. 2. Қызба мен асқын қызынудың айырмашылығы
2. 3. Геморрагиялық қызба аурулары
2. 4. Қызба кезінде ағзалар мен жүйелердің өзгерістері
ІІІ. Қорытынды:
ІV. Пайдаланылған әдебиеттер тізімі:
Кіріспе
Қызба
Иифекциялық қызба бактериялардың, вирустардың, қарапайым жануарлардың, саңырауқұлақтардың әсерлерінен дамиды. Бейинфекциялық қызба тіндердің бүлінуіне әкелетін сыртқы және ішкі ықпалдардың әсерлерінен пайда болады. Бұларға: күйік, жарақат, инфаркт, қан қүю, ішке қан құйылу, аллергия, ісік өсу, цирроз т. б. жатады.
Қызбаның даму жолдарында пирогендік заттар маңызды орын алады. Олар: экзогендік және эндогендік (лейкоциттік) болып екіге бөлінеді. Экзогендік пирогендер деп микробтардың тіршілігінен немесе олардың ыдырауынан пайда болатын заттарды айтады.
Қызба дамуында жоғарыда келтірілген пирогендермен бірге организмнің даралық реактивтілігі мен иммундық жүйесінің маңызы үлкен. Кейбір аурулар кездерінде температураның көтерілмеуі, ал кейде тым қатты көтерілуі мүмкін. Мысалы, қарттарда және қатты жүдеген адамдарда крупозды пневмония қызбасыз және ауыр түрде өтеді. Бұл организмнің жалпы тезімділігі төмендеуімен, энергия түзуге қажетті заттардың жеткіліксіздігімен, зат алмасу қарқынының төмендеуімен және эндогендік пирогендердің түзілуі бүзылуына байланысты. Қызба дамуында пирогендерден басқа заттардың да, әсіресе гормондардың, маңызы үлкен. Тиреотоксикоз кезінде жүқпалы аурулар тым қатты ет ысуымен қабаттасады. Гипотиреоз кезінде қызба сирек дамиды. Глюкокортикоидтар ет ысуын азайтады.
Дене қызымының бір деңгейде ұсталып тұруы денеде орталық нерв жүйесінің әрекеттерімен қадағаланатын жылу өндіру мен оны сыртқа шығару процестерінің тепе-теңдігімен қамтамасыз етіледі.
Жылу өндіру мен оны сыртқа шығару орталықтары алдыңғы және артқы гипоталамуста бөлек орналасқанына қарамай, олар өзара тығыз байланыста болады.
Қызбаның сатылары
Қызба үш сатыда өтеді:
1. температураның көтерілуі сатысы (stadium incrementum)
2. температураның жоғары деңгейде тұрақтану сатысы (stadium decrementum)
3. Қызбаның әр сатысынды организмде дене қызымының реттелуі әртүрлі болады.
Температураның көтерілу сатысы. Қызба кейде температураның жоғары деңгейге кенет, бірнеше сағаттың ішінде, тез (крупнозды пневмония, грипп, безгек, бөртпе сүзек т. б. ), кейдке біртіндеп, бірнеше күннің ішінде (іш сүзегі, қызылша т. б. ) көтерілуімен басталады. Бұл кезде организмнен жылудың сыртқа шығарылуы шектеледі де, денеде жылу өндірілу одан басым болады. Шеткі қан тамыр тамырларының жиырылуынан және тер шығудың тежелуінен жылудың сыртқа берілуі төмендейді. Бұлшық еттерде, бауырда және ішкі ағзаларда тотығу-тотықсыздану үрдістерінің артуына байланысты организмде жылу өндірілуі күшейеді. Жиырылған қылтамырдарда қан айналымы баяулауына байланысты тері бозарып, суыйды. Арқаның, қолдардың, кейде жалпы қаңқа еттерінің талщықтарының еріксіз жиырылулары болады. Бұл кезде жиырылған еттер пайдалы жұмыс атқармайды, тоңу сезімімен, дененің қалтырауымен қабаттасады.
Температураның жоғары деңгейде тұрақтану сатысы. Қызбаның 1-сатысынан кейін дене қызымы белгілі деңгейге көтеріліп, сол деңгейде біршама уақыт тұрақтанып тұрады. Бұл кезде жылудаң сыртқа шығарылуы да жоғарлайды; тері қызарып, ысыйды, тыныс алу жиілейді. Бұл сатыда қызбаның келесі түрлерін ажыратады:
- шамалы (субфебрильдік) қызба -дене қызымының 380С-ға дейін көтерілуі
- орташа қызба -38-390С
- қатты қызба -39-400С
- асқын (гиперпиреттік) қызба -410С-тен астам көтерілуі.

Гемморагиялық стафилококк
Температураның қалыпты деңгейге түсу сатысы . Қызбаның бұл сатысы жылудың сыртқа шығарылуының жылу өндірілуден басым болуымен сипатталады. Осының нәтижесінде дене қызымы қалыпты деңгейге дейін төмендейді. Организмде жиналған жылу тері тамырларының кеңуі, терлеу мен тыныстың жиілеуі арқылы сыртқа шығарылады. Температураның түсуі екі жолмен болуы ықтимал:1. біртіндеп, лизистік (бірнеше тәулік ішінде) түсуі; 2. күрт (кризистік) түсуі.
Қызба мен асқын қызынудың айырмашылығы
Қызба мен гипертермия кездеріндегі темрератураның көтерілуі жолдары мен себептері әртүрлі. Гипертермияның негізгі себебі сыртқы орта температурасының жоғары көтерілуінен болады. Ол ыстық өндірістерде істейтін жұмысшыларда, ыстық климаты бар аймақтардың тұрғындарында т. б. жағдайларда байқалады. Бұл кезде сыртқы ортада температура көтерілуіне организмнің компенсациялық механизмдері белгілі уақытқа дейін қарсы тұрады. Терінің қан тамырлары кеңиді, тыныс алу және жүрек соғысы жиілейді. Артынан бұл компенсациялық механизмдер жеткіліксіз болып, дене қызымы еөтеріледі, гипертермия дамиды.
Қызба кезінде термореттеу механизмдерінің дене қызымын көтеруге бағытталған., ал гипертермия кезінде термореттеу механизмдері оған қарсы тұрады. Дене температурасының көтерілуі кезінде пирогендердің қатысымен болпды, ал гипертермия кезінде олардың маңызы болмайды. Кейде гипертермияны зат алмасуларын арттыратын дәрі-дәрмектердің көмегімен алуға болады.
Геморрагиялық қызба аурулары
Бұл көптеген жедел жұқпалы аурулар тобы, осыларды біріктіретіні вирусты этиологиялығы, табиғи ошақтығы, айқын капиллярдың эндотелиінің зақымдалуы, геморрагиялық синдромының дамуы.
Қазіргі уақытта ең кемінде 13 нозологиялық түрлері белгілі.
Геморрагиялық синдром ішіндегі белгілі төрт вирус тұқымдастары:
Аренавирустар (Arenaviridae)
- Ласс вирусы ( Ласса қызбасы )
- Хунин вирусы (Аргентин қызбасы)
- Мачупо вирусы (Боливий қызбасы)
- Гуанарито вирусы (Венесуэль қызбасы)
- Сэбия вирусы (Бразиль қызбасы)
Буньявирусы (Bunyaviridae)
- Вирусты геморрагиялық қызбаның бауырлық синдромы
- Крым-Конго қызбасы вирусы
- Рифт мекенінің вирусты қызбасы
1.
 2.
2.
 3.
3.

Филовирустар(Filoviridae)
- Марбург вирусы
- Эбола вирусы
1.
 2.
2.

Флавивирусы (Flaviviridae)
- леса Киассанур ауруының вирусы (Къясанур)
- омск геморрагиялық қызбасының вирусы
- Сары қызба вирусы
- денге қызбасының вирусы
Флавивирусы (Flaviviridae)
Диагностикасы. Диагнозды серологиялық және вирусологиялық зерттеу әдістері дәлелдейді. Серодиагностика үшін антидене анализінің келесі әдістерін қолданады: РН (нейтрализациялау реакциясы) РТГА (гемагглютинацияны тежеу реакциясы) РСК (комплемент байланыстырушы реакциясы ) РИА (радиоиммунды анализ) жұпты сарысулар.
Этиологиясы және эпидемиолгиясы:
Этиологиялық факторы - арбовирустар. Осы ауруларды зерттеп жазған XX ғасырда.
Эпидемиология бойынша жіктелуі (М. П. Чумаков, 1977 ж. ұсынған) :
1. Кене арқылы жұғатын геморрагиялық қызбалар: Қырымдық, Омскілік, Кьясанур жақтық.
2. Маса арқылы жұғатын геморрагиялық қызбалар: Денге қызбасы, Чикунгунья, Пифт-Вали қызбалары.
3. Контагиозды зоонозды геморрагиялық қызбалар: бүйрек синдромымен, аргентиналық, боливийялық, Ласса, Марбург, Эбол қызбалары.
Барлық ГҚ - симптомокомплексы - ол біртіндеп не болмаса жедел пайда болатын жалпы улану белгілері, 3 күн бойынша сақталады, содан кейін қысқа уақытқа (бірнеше сағат) жағдайы жақсарып, тағыда 3-4 күн ауру белгілері күшейеді. Осы кезенде қан кету пайда болады, әсіресе тері астына, мұрыннан, қызыл иектен, көздің конъюктивасынан, ішкі мүшелерден (қан құсу, мелена, гематурия, метроррагия) .
Геморрагаялық синдромның ауырлық дәрежесі әртүрлі: жеңілден ауыр жағдайға дейін, өліммен аяқталатын.
Жиі кардиоваскулярлы синдром дамуы мүмкін, шок пен коллапска дейін.
Аурудың басқа белгілері де дамиды ол:
сусыздану, гемолиз, сарғаю, орталық жүйке жүйесінің зақымдануы, екіншілік бактериалды флора қалыптасуы.
Айтып кеткен жалпы белгілермен қатар қызбаға өзіне тән ерекшелігі бар.
Сары қызбада
- бауыры зақымданады, және сарғыштық пайда болады, денеге қызбада - буындары мен бұлшық еттері; Марбурга қызбасында - диарея, бүйрек синдромымен өтетін қызбада - бүйрегі зақымдалады.
Қызбалармен ауырады эндемия не болмаса спорадикалық түрде Геморрагиялық аурулар көп кездеспейтін аурулар, бірақ проблемалы ауру деп саналады: эпидемия тудыруы мүмкін, өлім көрсеткіші жоғарғы дәрежеде емдеудегі және алдын алудағы қиындығы шешілмеген.
ҚР - геморрагиялық қызбалардың 3 түрі кездеседі:
қырымдық, омскілік,
бүйрек синдромымен өтетін қызба.
Осы аурулардың қоздырғышы арбовирус, иесі болып табылады. Hyalomma asiaticum кене. Табиғи ошақтарда үй жануарларда 100% жағдайларда кене табылады. Кенелердің белсенділігі сәуір - мамыр айларында, және қыркүйек - қазан айларында анықталады. Аурулардың саны да көбейеді көктем жаз айларында, әсіресе мамырда
Патогенезі.
Вирус денеге кене шаққанда тері арқылы түседі. Вирустың тропизмдік қасиеті гипоталамикалық ортаға және вазотроптік (зақымдайды бүйрек, бауыр және ОЖЖ ұсақ тамырларының эндотелиін) . Осының нәтижесінде қантамырлардың өткізгіштігі жоғарылайды, қанның ұю жүйесінің қызметі бұзылады «ТІШҚҰң- дамиды. Сонымен қатар сүйек миының клеткаларының өсуі басылады, бауырдың функциясы бұзылады.
Клиникасы. ҚГҚ-да инкубациялық кезең - 12 күнге дейін созылуы мүмкін, бірақ орта есеппен - 5 күн.
Аурудың ағымында 3 кезеңді ажыратады:
- 1-бастапқы (геморрагия алды), ұзақтығы 2 күн
- 2-қызған кезеңі (геморрагиялық), 4-7 күндей
- 3-реконвалесценция кезеңі, 15-30 күндей
- 105 аурудың ішінде - 51% орташа ауырлық, 34% - ауыр, 11, 4 жеңіл түрімен ауырған.
Ауру жедел басталады, қатты басының ауруымен, айқын әлсіздік, барлық денесі қақсайды, буындары - сүйектері, белі ауырады, кейбірде іші де ауруы мүмкін, ұйқысы бұзылады, тәбеті төмендейді, жүрек айнуы пайда болады (20% жағдайда), құсу (20%) кейбірде бірінші күннен бастап геморрагиялық синдром көрінеді, мұрнынан (12%), қызыл иектен (14%) қан кету, теріде петехиялар болады (6%) . Дене қызуы тез арада 39-40-41° дейін көтеріледі, қызу мен қалтырау ауысып тұрады.
Ауруды қараған кезде бастапқы кезеңде табылады бетінің қызаруы (37%), мойын, денесінің жоғарғы жағы қызарады (капюшон синдромы) - 26%, конъюктивасының қызаруы (12%), склерасының қызаруы - 33%, ауыз-жұтқыншақтың қызаруы - 12%. Тілін үлпек басқан және ісінген - 30% ауруларда, қан тамыр-жүрек жағынан - брадикардия, гипотония, жүрек үндерінің баяулауы байқалады. Кейбірде гепатомегалия болады. Шеткері қанда бастапқы кезеңде эритроциттер, гемоглобин, гематокрит көбейеді, лейкопения, нейтрофиллезбен, солға жылжумен, ЭТЖ- жоғарылайды. Орташа және ауыр түрлерінде ПИ төмендейді (45%-ке дейін) . Зәрде - лейкоцитурия, протейнурия. Бастапқы кезеңінің ұзақтылығы ауырлық дәрежесіне байланысты. Жеңіл түрде қызған кезеңінен белгілеу қиын, аурудың барлық ұзақтығы 7-8 күндей. Орташа ауырлықта бастапқы кезеңі 3 күнге дейін, ал ауыр жағдайларда қысқарады 1-2 күнге дейін.
Қызған кезеңі созылады 4 күннен 7 күнге дейін. Осы кезеңде дене қызуы өте жоғарылайды, улану белгілері күшейеді, бас ауруы айқын, тәбеті одан сайын төмендейді, анорексияға дейін. Геморагиялық синдром дамиды: мұрнынан қан кету, қызыл иекген де, сиректеу жатырдан, асқазан-ішек жолдарынан, бүйректен қан кетеді, геморрагиялық бөртпе, ине салған жерлерде гематома. Беті, мойны қызарады, склерасының инъекциясы көрінеді.
Қан тамыр - жүрек жүйесі жағынан өзгерістер бастапқы кезеңдегі сияқты:
брадикардия, гипотония, жүрек үндерінің баяулауы, гепатомегалия
байқалады.
Асқазан-ішек жолдары жағынан -
жүрек айну, құсу, ішінде ауру сезім, эпигастрий аймағы қызады, содан кейін асқазан-ішектен қан
кетеді. Қызған кезеңде бұлшық еттерінің, буындарының ауырғаны әлсірейді. Кейбір ауруларда есі ауысады, сопор комаға дейін барады.
Қызбаның түрі КХҚ ауырғандардың тұрақты не болмаса дұрыс емес, кейбірде ремитирлеуші. Ең жоғары дәрежеге жетеді ауруының бірінші екі күндерінде 40% ауырларда қызбасы екі өркешті түрдей, арасындағы төмендеуі 4-5 күні байқалады, сонда көбінесе геморрагиялық синдром басталады. Дене қызуының төмендеуі көбінесе кризолитикалық.
қан және зәр анализіндерінде өзгерістер айқынырақ. Қан кетудің әсерінен гемоглобин, эритроцит, тромбоцит саны төмендейді. Кейбірде тромбоциттер бірен-сараң кездеседі. 50% ауруларда лейкопения сақталады, бірақ басқаларында лейкоциттер және лимфоциттер өсуде. ЭТЖ жоғары да төмен де байқалады.
Зәрде
-
протейнурия, цилиндрурия, гематурия.
Коагулограммада жиі гиперкоагуляция. Биохимиялық анализде 5-10% ауруларда айқын емес гипербилирубинемия гемолиз бен байланысты, АЛТ, кейбірде қалдық азот көбейеді.
Реконвалесценция кезеңі басталады:
ауырғаннан бастап орташа және жеңіл түрлерінде 7-ші күннен, ал ауыр түрінде - 9-10 күннен. 15% ауруларда әлі де геморрагиялық синдром сақталады, бірақ тек қана теріде ғана 1/3 - ауруларда әлі шамалы беті қызарған, склерасының инъекциясы (1/4) байқалады. Аурулардың көбінде аздап басы аурады, қысқа уақытта субфебрилитет болады, әлсіздік, шаршағыштық, жалпы қан анализінде - анемия сақталады, алдында геморрагиялық синдром айқын болса, кейбіреулерде ЭТЖ әлі жоғары. Стационардан шығатын кезде тек қана жұмысқа жарайтындар жеңіл түрімен ауырғандарғана.
Дифференциальді диагностика:
1. Басқа геморрагиялық қызбалармен
2. Геморрагиялық васкулитпен
3. Тромбоцитопениялық пурпурамен
4. Лептоспирозбен
5. Бөртпе сүзегімен
6. Жедел лейкозбен
7. Сепсиспен
Қызба кезінде ағзалар мен жүйелердің өзгерістері
... жалғасы- Іс жүргізу
- Автоматтандыру, Техника
- Алғашқы әскери дайындық
- Астрономия
- Ауыл шаруашылығы
- Банк ісі
- Бизнесті бағалау
- Биология
- Бухгалтерлік іс
- Валеология
- Ветеринария
- География
- Геология, Геофизика, Геодезия
- Дін
- Ет, сүт, шарап өнімдері
- Жалпы тарих
- Жер кадастрі, Жылжымайтын мүлік
- Журналистика
- Информатика
- Кеден ісі
- Маркетинг
- Математика, Геометрия
- Медицина
- Мемлекеттік басқару
- Менеджмент
- Мұнай, Газ
- Мұрағат ісі
- Мәдениеттану
- ОБЖ (Основы безопасности жизнедеятельности)
- Педагогика
- Полиграфия
- Психология
- Салық
- Саясаттану
- Сақтандыру
- Сертификаттау, стандарттау
- Социология, Демография
- Спорт
- Статистика
- Тілтану, Филология
- Тарихи тұлғалар
- Тау-кен ісі
- Транспорт
- Туризм
- Физика
- Философия
- Халықаралық қатынастар
- Химия
- Экология, Қоршаған ортаны қорғау
- Экономика
- Экономикалық география
- Электротехника
- Қазақстан тарихы
- Қаржы
- Құрылыс
- Құқық, Криминалистика
- Әдебиет
- Өнер, музыка
- Өнеркәсіп, Өндіріс
Қазақ тілінде жазылған рефераттар, курстық жұмыстар, дипломдық жұмыстар бойынша біздің қор #1 болып табылады.



Ақпарат
Қосымша
Email: info@stud.kz



